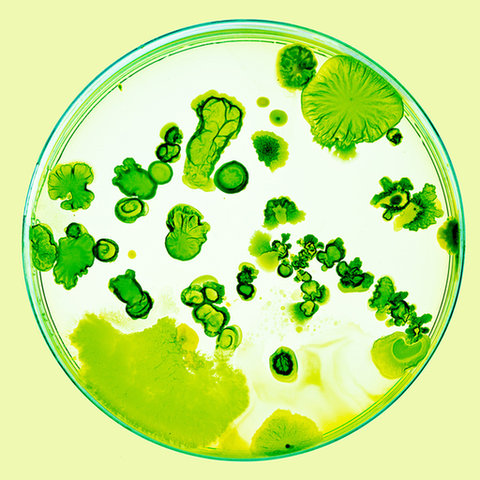

How is the pharma industry addressing rare conditions such as EDS?

How can the pharma industry improve sustainability in 2020?

What happens to virus whistleblowers after they blow the whistle?

Gilead’s remdesivir has emerged as a promising early hope for treating Covid-19

Intellectual property has become a bit of a grey area in pursuit of Covid-19 treatments

Recce Pharma may have discovered the next frontier in the fight against AMR
A look inside the longest running collection of bacteria type cultures

Puberty blockers are a controversial option for transgender children

Why is horseshoe crab blood so difficult to replace in clinical trials?

A look back over the history of innovations in antibody-based therapeutics
